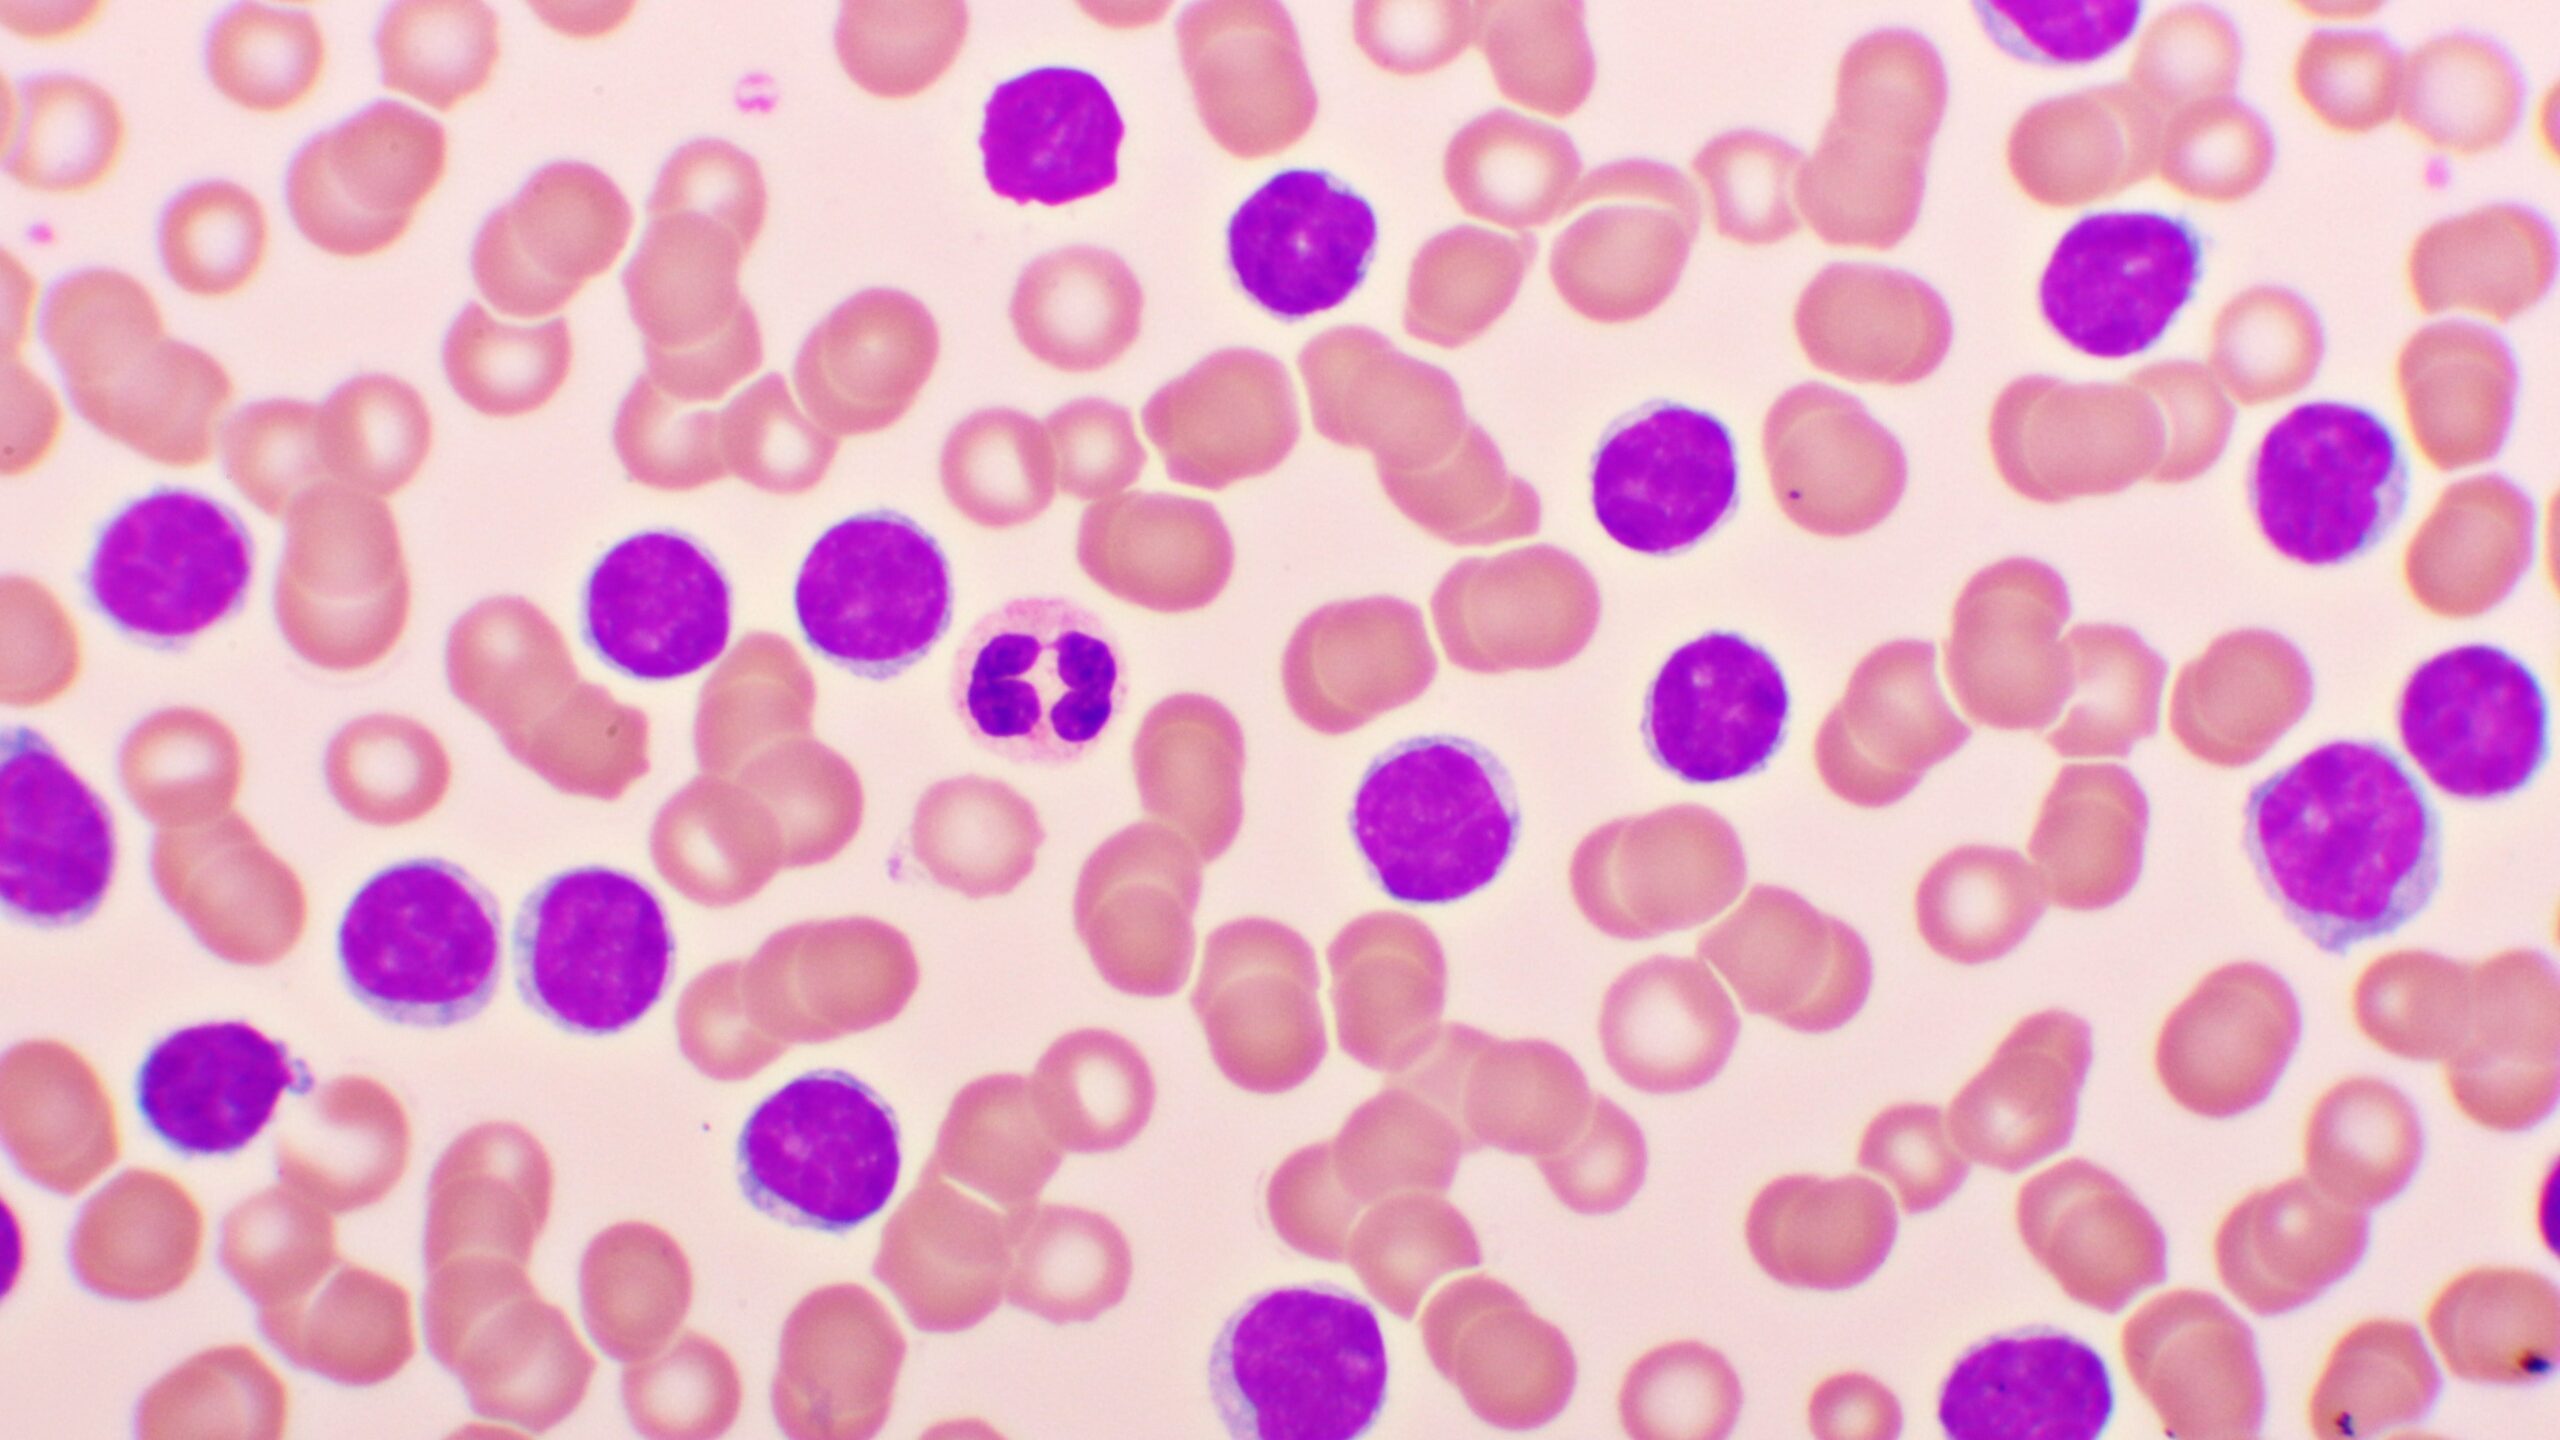

Acalabrutinib-venetoclax (AV) demonstrated superior progression-free survival (PFS) versus standard dosing protocols of fludarabine-cyclophosphamide-rituximab (FCR) or bendamustine-rituximab (BR) in patients with treatment-naive (TN) chronic lymphocytic leukemia (CLL). Researchers of the AMPLIFY Trial presented the findings at the ASH Annual Meeting, emphasizing that AV and acalabrutinib-venetoclax-obinutuzumab (AVO) provided deep and durable responses with manageable safety profiles.
“In patients with TN-CLL, both continuous Bruton tyrosine kinase inhibitor (BTKi) monotherapy and fixed-duration venetoclax-based combination regimens are highly effective. However, existing fixed-duration regimens using first-generation BTKis have important efficacy and/or safety limitations,” wrote the authors, led by Jennifer R. Brown, MD, PhD, of Dana-Farber Cancer Institute, Boston, Massachusetts.
AMPLIFY is the first randomized trial to evaluate a fixed-duration venetoclax regimen with a second-generation BTKi. It enrolled patients with TN-CLL aged 18 years or older with Eastern Cooperative Oncology Group performance status scores of 2 or lower but did not have a del(17p) or TP53 mutation. The researchers randomized 867 participants to receive one of three regimens:
- AV (n=291): oral acalabrutinib 100 mg twice daily for cycles 1–14 and oral venetoclax once daily for cycles 3–14, with a five-week dose ramp-up (20, 50, 100, 200, and 400 mg);
- AVO (n=286): AV dosing as described above, plus intravenous obinutuzumab 1,000 mg in cycles 2−7; or
- FCR/BR (n=290): investigator’s choice of FCR or BR.
The population had amedian age of 61 years, 64.5% were male, and 58.6% had unmutated IGHV (immunoglobulin heavy chain variable region gene).
At a median follow-up of 41 months, AV and AVO improved PFS over the control group. Neither the AV nor AVO groups reached median PFS, which was 47.6 months for FCR/BR. The researchers estimated 36-month PFS rates at 76.5% for AV, 83.1% for AVO, and 66.5% for FCR/BR. Overall response rate also was higher with AV (92.8%; 95% confidence interval [CI], 89.4–95.4) and AVO (92.7%; 95% CI, 89.2–95.3) versus FCR/BR (75.2%; 95% CI, 70.0–79.9. OS trended higher in the AV group.
Serious adverse events (AEs) occurred in 24.7% of AV patients, 38.4% of AVO patients, and 27.4% of FCR/BR patients. The most common grade 3 or higher AE was neutropenia (26.8% AV, 35.2% AVO, and 32.4% FCR/BR). Other AEs reported were tumor lysis syndrome, atrial fibrillation, and hypertension. Deaths occurred in 18 patients in the AV group, 37 in the AVO group, and 42 in the control group, many of which were COVID-related.
The authors concluded that AV offers “the first all-oral fixed-duration regimen that combines venetoclax with a second-generation BTKi in fit patients with TN CLL.”
https://ash.confex.com/ash/2024/webprogram/Paper200701.html
Reference
Brown JR, Seymour JF, Jurczak W,, et al. Fixed-duration acalabrutinib plus venetoclax with or without obinutuzumab versus chemoimmunotherapy for first-line treatment of chronic lymphocytic leukemia: interim analysis of the multicenter, open-label, randomized, phase 3 AMPLIFY Trial. Abstract #1009. Presented at the 66th American Society of Hematology Annual Meeting and Exposition; December 7–10, 2024; San Diego, California.